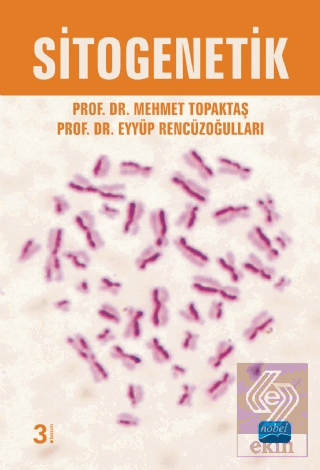
Sitogenetik

Kalıtsal değişmelerin sebeplerini, kromozomları ve kromozoma dayalı oluşumları inceleyerek açıklayan sitogenetik biliminin doğum yılı olarak Hofmeister'in kromozomları ilk gözlediği yıl olan 1840 yılı kabul edilir. Bu bilim dalının temel inceleme materyali ökaryotik canlı kromozomu, yararlandığı alet ise mikroskoptur. Kromozom elde etme ve özellikle bandlama metotlarının bulunması ile birlikte mikroskopi tekniklerinin artması bu bilim dalının ilerlemesinin yolunu açmıştır. Bu tekniklerin büyük bir çoğunluğu bu kitapta en ince ayrıntılarıyla yer almaktadır. Ayrıca kitapta konular bol şekillerle açıklanmış, bazı konulardaki şekiller kendi çalışmalarımız sırasında saptadığımız sitogenetik anormallikleri içeren orijinal fotoğraflardan ibarettir.
Bu kitap, sitogenetik çalışma yapmak isteyen bilim insanının ve konuya merak duyan kişilerin kolaylıkla uygulayabilecekleri sitogenetik metotların ince ayrıntılarını da içermektedir. Bu kitabın hedef kitlesi:
• Sitogenetik çalışma yapmak isteyen öğretim üyesi,
• Bu konuda çalışmaya başlayacak olan lisansüstü öğrencileri,
• Fen ve Fen-Edebiyat Fakültelerinin Biyoloji, Eğitim Fakültelerinin Biyoloji ve Fen Bilgisi Öğretmenliği, Tıp, Veteriner Hekimliği, Ziraat, Eczacılık Fakültelerinin lisans öğrencileri,
• Liselerde biyoloji, ilköğretim okullarında Fen Bilgisi öğretmenleri ve
• Sitogenetiğe ilgi duyan her meslekten kişilerdir.
Özet olarak bu kitabın, gerek bitki gerekse insan ve hayvanlarda özellikle uygulamaya yönelik sitogenetik ve karyolojik araştırma yapmak isteyenlerin her zaman başvurma ihtiyacını duyabileceği temel bir kitap niteliğinde olduğu görüşündeyiz.
Kalıtsal değişmelerin sebeplerini, kromozomları ve kromozoma dayalı oluşumları inceleyerek açıklayan sitogenetik biliminin doğum yılı olarak Hofmeister'in kromozomları ilk gözlediği yıl olan 1840 yılı kabul edilir. Bu bilim dalının temel inceleme materyali ökaryotik canlı kromozomu, yararlandığı alet ise mikroskoptur. Kromozom elde etme ve özellikle bandlama metotlarının bulunması ile birlikte mikroskopi tekniklerinin artması bu bilim dalının ilerlemesinin yolunu açmıştır. Bu tekniklerin büyük bir çoğunluğu bu kitapta en ince ayrıntılarıyla yer almaktadır. Ayrıca kitapta konular bol şekillerle açıklanmış, bazı konulardaki şekiller kendi çalışmalarımız sırasında saptadığımız sitogenetik anormallikleri içeren orijinal fotoğraflardan ibarettir.
Bu kitap, sitogenetik çalışma yapmak isteyen bilim insanının ve konuya merak duyan kişilerin kolaylıkla uygulayabilecekleri sitogenetik metotların ince ayrıntılarını da içermektedir. Bu kitabın hedef kitlesi:
• Sitogenetik çalışma yapmak isteyen öğretim üyesi,
• Bu konuda çalışmaya başlayacak olan lisansüstü öğrencileri,
• Fen ve Fen-Edebiyat Fakültelerinin Biyoloji, Eğitim Fakültelerinin Biyoloji ve Fen Bilgisi Öğretmenliği, Tıp, Veteriner Hekimliği, Ziraat, Eczacılık Fakültelerinin lisans öğrencileri,
• Liselerde biyoloji, ilköğretim okullarında Fen Bilgisi öğretmenleri ve
• Sitogenetiğe ilgi duyan her meslekten kişilerdir.
Özet olarak bu kitabın, gerek bitki gerekse insan ve hayvanlarda özellikle uygulamaya yönelik sitogenetik ve karyolojik araştırma yapmak isteyenlerin her zaman başvurma ihtiyacını duyabileceği temel bir kitap niteliğinde olduğu görüşündeyiz.
| Taksit Sayısı | Taksit tutarı | Genel Toplam |
|---|---|---|
| Tek Çekim | 155,80 | 155,80 |
| 2 | 81,02 | 162,03 |
| 3 | 56,09 | 168,26 |
| Taksit Sayısı | Taksit tutarı | Genel Toplam |
|---|---|---|
| Tek Çekim | 155,80 | 155,80 |
| 2 | 81,02 | 162,03 |
| 3 | 56,09 | 168,26 |